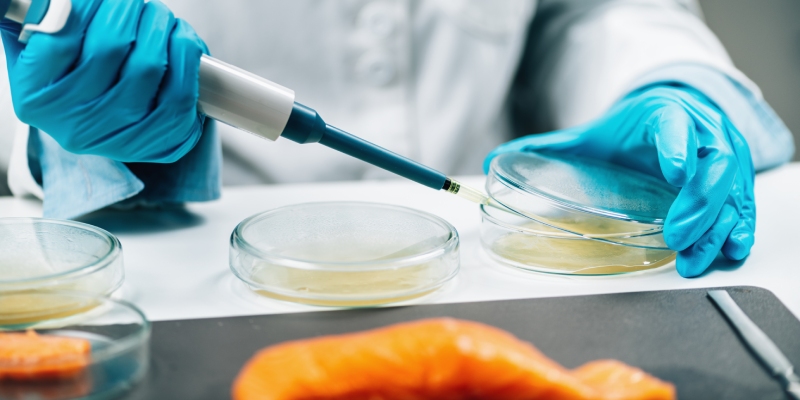
estudios de vida util en relacion a Listeria monocytogenes

La Agencia Española de Seguridad Alimentaria y Nutrición (AESAN) ha publicado recientemente el "Documento de orientación para la verificación de estudios de vida útil en relación con Listeria monocytogenes en alimentos listos para el consumo", clave para reducir el riesgo de listeriosis y cumplir con la normativa de seguridad alimentaria.
Verificación de estudios de vida útil en relación con Listeria monocytogenes
Este documento, aprobado por la Comisión Institucional de AESAN, es una herramienta clave para prevenir el riesgo de listeriosis causada por el consumo de alimentos listos para el consumo (ALC).
Los objetivos principales del documento son:
- Proporcionar información y orientaciones a los operadores de empresas alimentarias (OEA) que fabrican, envasan o reenvasan alimentos listos para el consumo (ALC) para que desarrollen estudios de vida útil que garanticen la seguridad frente a Listeria monocytogenes (Lm).
- Servir de guía a las Autoridades Competentes para verificar que dichos estudios de vida útil sean adecuados conforme a la normativa vigente.
- Funcionar como recurso técnico para laboratorios y asesores implicados en estos estudios.
El nuevo documento de guía proporciona información relevante al OEA sobre la evaluación de si un alimento listo para consumir (RTE) favorece el crecimiento de Listeria monocytogenes y, si corresponde, cual de los criterios que establece el Reglamento (CE) nº 2073/2005 se le aplican: el criterio 1.2a (límite de 100 ufc/g de Lm durante toda su vida útil) o el criterio1.2b. (no detección en 25 g durante toda su vida útil).
Recordemos que este último será aplicable desde el 1 de julio de 2026.

Responsabilidades del OEA
Los OEA deben investigar exhaustivamente diversos factores, como se describe en el documento, para comprender plenamente el riesgo de Listeria monocytogenes en relación con los alimentos que producen, ya que la responsabilidad última de la seguridad del producto recae en el operador de la empresa alimentaria. Sus obligaciones incluyen:
- Determinar y validar la vida útil del alimento en relación con el criterio de seguridad de Lm antes de ponerlo en el mercado.
- Cumplir con los criterios microbiológicos y aplicar medidas correctoras (como la retirada de producto) si los resultados son insatisfactorios.
- Realizar muestreos ambientales en zonas de trabajo y equipos para controlar la persistencia del patógeno.
- Documentar y conservar todas las pruebas de validación y verificación de la vida útil asignada al producto para que estén disponibles ante las autoridades.
- Revisar los estudios ante cualquier cambio significativo en el producto, proceso o envase.
- Colaborar con laboratorios y asesores para que las pruebas realizadas sean representativas de la realidad de su proceso productivo.
Clasificación de los alimentos según el riesgo
No todos los ALC presentan el mismo riesgo. La guía establece una caracterización clara basada en el potencial de crecimiento de Listeria monocytogenes:
- Alimentos que NO favorecen el crecimiento: Se incluyen productos con características que limitan intrínsecamente a la bacteria, como un pH muy ácido (≤ 4,4), una actividad de agua muy baja (aw ≤ 0,92), o una combinación de pH ≤ 5,0 y aw ≤ 0,94. También se consideran en esta categoría los productos con una vida útil inferior a 5 días.
- Alimentos que SÍ favorecen el crecimiento: Aquellos que no cumplen los parámetros anteriores y permiten que Lm se multiplique durante su almacenamiento.
El OEA debe definir detalladamente el producto (composición, formato, tratamientos térmicos, etc.) para su correcta caracterización.
Determinación, validación y verificación de la vida útil
La vida útil segura es el periodo en el que el alimento permanece libre de riesgos bajo condiciones previsibles de uso.
- La determinación de la vida útil se inicia identificando las características fisicoquímicas y consultando bibliografía científica o datos históricos.
- La vida útil se valida mediante la obtención de pruebas que demuestren que el criterio de seguridad se cumplirá (ej. Lm se mantiene <100 ufc/g). Si la bibliografía no es suficiente, se deben emplear modelos de microbiología predictiva, ensayos de desafío (challenge tests) o estudios de durabilidad bajo el "peor escenario posible" de temperatura .
- Una vez validada la vida útil, es esencial verificar el proceso mediante la monitorización de la presencia de Lm en el entorno y el análisis regular de los productos alimenticios para comprobar si el patógeno está presente (y en qué concentración) al final de la producción y hasta el final de su vida útil.
Cambio normativo a partir de julio de 2026
A partir del 1 de julio de 2026, si una empresa no cuenta con estudios de vida útil sólidos y validados que garanticen que Listeria monocytogenes no superará las 100 ufc/g al final de la vida útil del producto, se aplicará el criterio más estricto: «Listeria monocytogenes no detectado en 25 g», que deberá cumplirse durante toda la vida comercial del producto.
El documento hace referencia a esta actualización del criterio de seguridad para alimentos que favorecen el crecimiento de Lm:
- Si un OEA no dispone de estudios de vida útil validados que demuestren que no se superarán las 100 ufc/g, deberá aplicar el criterio de «ausencia (no detección) en 25 g» durante toda la vida comercial del producto.
- Esta situación exige medidas de verificación extensiva y muestreos más frecuentes al final de la producción y de la vida útil para garantizar la seguridad del consumidor.
Referencia:
DOCUMENTO DE ORIENTACIÓN PARA LA VERIFICACIÓN DE ESTUDIOS DE VIDA ÚTIL EN RELACIÓN CON LISTERIA MONOCYTOGENES EN ALIMENTOS LISTOS PARA EL CONSUMO, AESAN, Aprobado en Comisión Institucional del 18 de marzo de 2026








